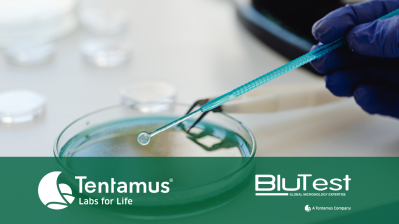
bacteriology

Bacteriology Testing for Disinfectants: Q&A on Methods, Standards and Results
Bacteriology plays a vital role in disinfectant testing, helping to ensure products are effective, safe, and fit for their intended use. In sectors such as healthcare, veterinary services, manufacturing, and general hygiene control, understanding how disinfectants perform against microorganisms is essential for managing risk and meeting regulatory requirements.
This article explores why bacteriology testing remains essential in modern disinfectant testing, the organisms involved, how testing is carried out, and why standards and results must be carefully interpreted.
Why Bacteriology Remains Essential in Modern Testing
We are surrounded every day by microorganisms, including bacteria and fungi. For the most part, these microorganisms are harmless and, in many cases, essential to everyday life — from food production such as bread, beer, and yoghurt to natural environmental processes.
However, there are situations where microorganisms can cause harm and lead to illness or contamination. This is why bacteriology remains a critical part of modern testing. By evaluating how effectively disinfectants act against specific microorganisms, bacteriology testing helps ensure that environments can be cleaned and controlled safely and reliably.
What Organisms Are Included in Disinfectant Testing Standards?
Disinfectant testing standards typically include a range of representative organisms. These microorganisms are selected based on how common they are and how they respond to different chemical agents. Using representative organisms allows laboratories to challenge disinfectants in a consistent and meaningful way.
In addition to those listed in standard methods, testing can also be carried out against specific organisms that may not be explicitly included in the standard. This is often done to support particular efficacy claims or to demonstrate effectiveness against organisms of concern in specific applications or environments.
Why Does Bacteriology Testing Take Several Days?
Bacteriology testing relies on accurately measuring the number of microorganisms present after a disinfectant has been applied and comparing these results to an untreated control. To do this, microorganisms are grown on agar plates, allowing visible colonies to develop.
Because microorganisms are microscopic, this growth process can take several days. Once colonies are visible and counted, additional checks are carried out to confirm that the test has been performed correctly. Controls are reviewed, results are verified, and reports are prepared before findings are released, ensuring accuracy and reliability.
What Does a Failed Bacteriology Result Really Mean?
A failed bacteriology result can occur for a number of reasons and does not always indicate that a disinfectant is ineffective overall. One common factor is that the concentration used during testing may not have been high enough, or that the selected contact time was too short.
Different disinfectants work in different ways. Some act very quickly against certain organisms, while others require longer exposure to achieve the desired level of effectiveness. Understanding the context of a failed result is therefore essential when reviewing outcomes and determining next steps.
Why Are There So Many Disinfectant Testing Standards?
There are many disinfectant testing standards because they are designed to reflect different sectors, uses, and real-world conditions. Standards may apply to medical, veterinary, or general-purpose environments, as well as to specific applications such as textiles or surface disinfection.
Medical sector standards, for example, allow disinfectants to be used in healthcare settings and often include challenging conditions that reduce disinfectant efficiency, such as higher soiling loads. Veterinary standards may focus on organisms relevant to animal health and can be conducted at lower temperatures to simulate outdoor or kennel cleaning conditions.
By tailoring standards to specific scenarios, bacteriology testing ensures disinfectants are assessed under conditions that closely match their intended use.
Conclusion
Bacteriology testing is a fundamental part of demonstrating disinfectant efficacy and supporting safe, effective hygiene practices across a wide range of sectors. By testing against representative and sector-specific microorganisms under controlled conditions, laboratories can provide reliable data that reflects real-world use.
Understanding why testing takes time, what results truly mean, and why different standards exist helps organisations make informed decisions when selecting and using disinfectants. With robust bacteriology testing in place, businesses can reduce risk, support compliance, and maintain confidence in their cleaning and disinfection processes.
If you have your own questions or would like to speak to the team about our bacteriology and disinfectant testing services, please contact us at HelloUK@tentamus.com!
These questions were answered by Dr. Tracy Rivett (nee Young), R&D Project Manager at BluTest Laboratories - A Tentamus Company.